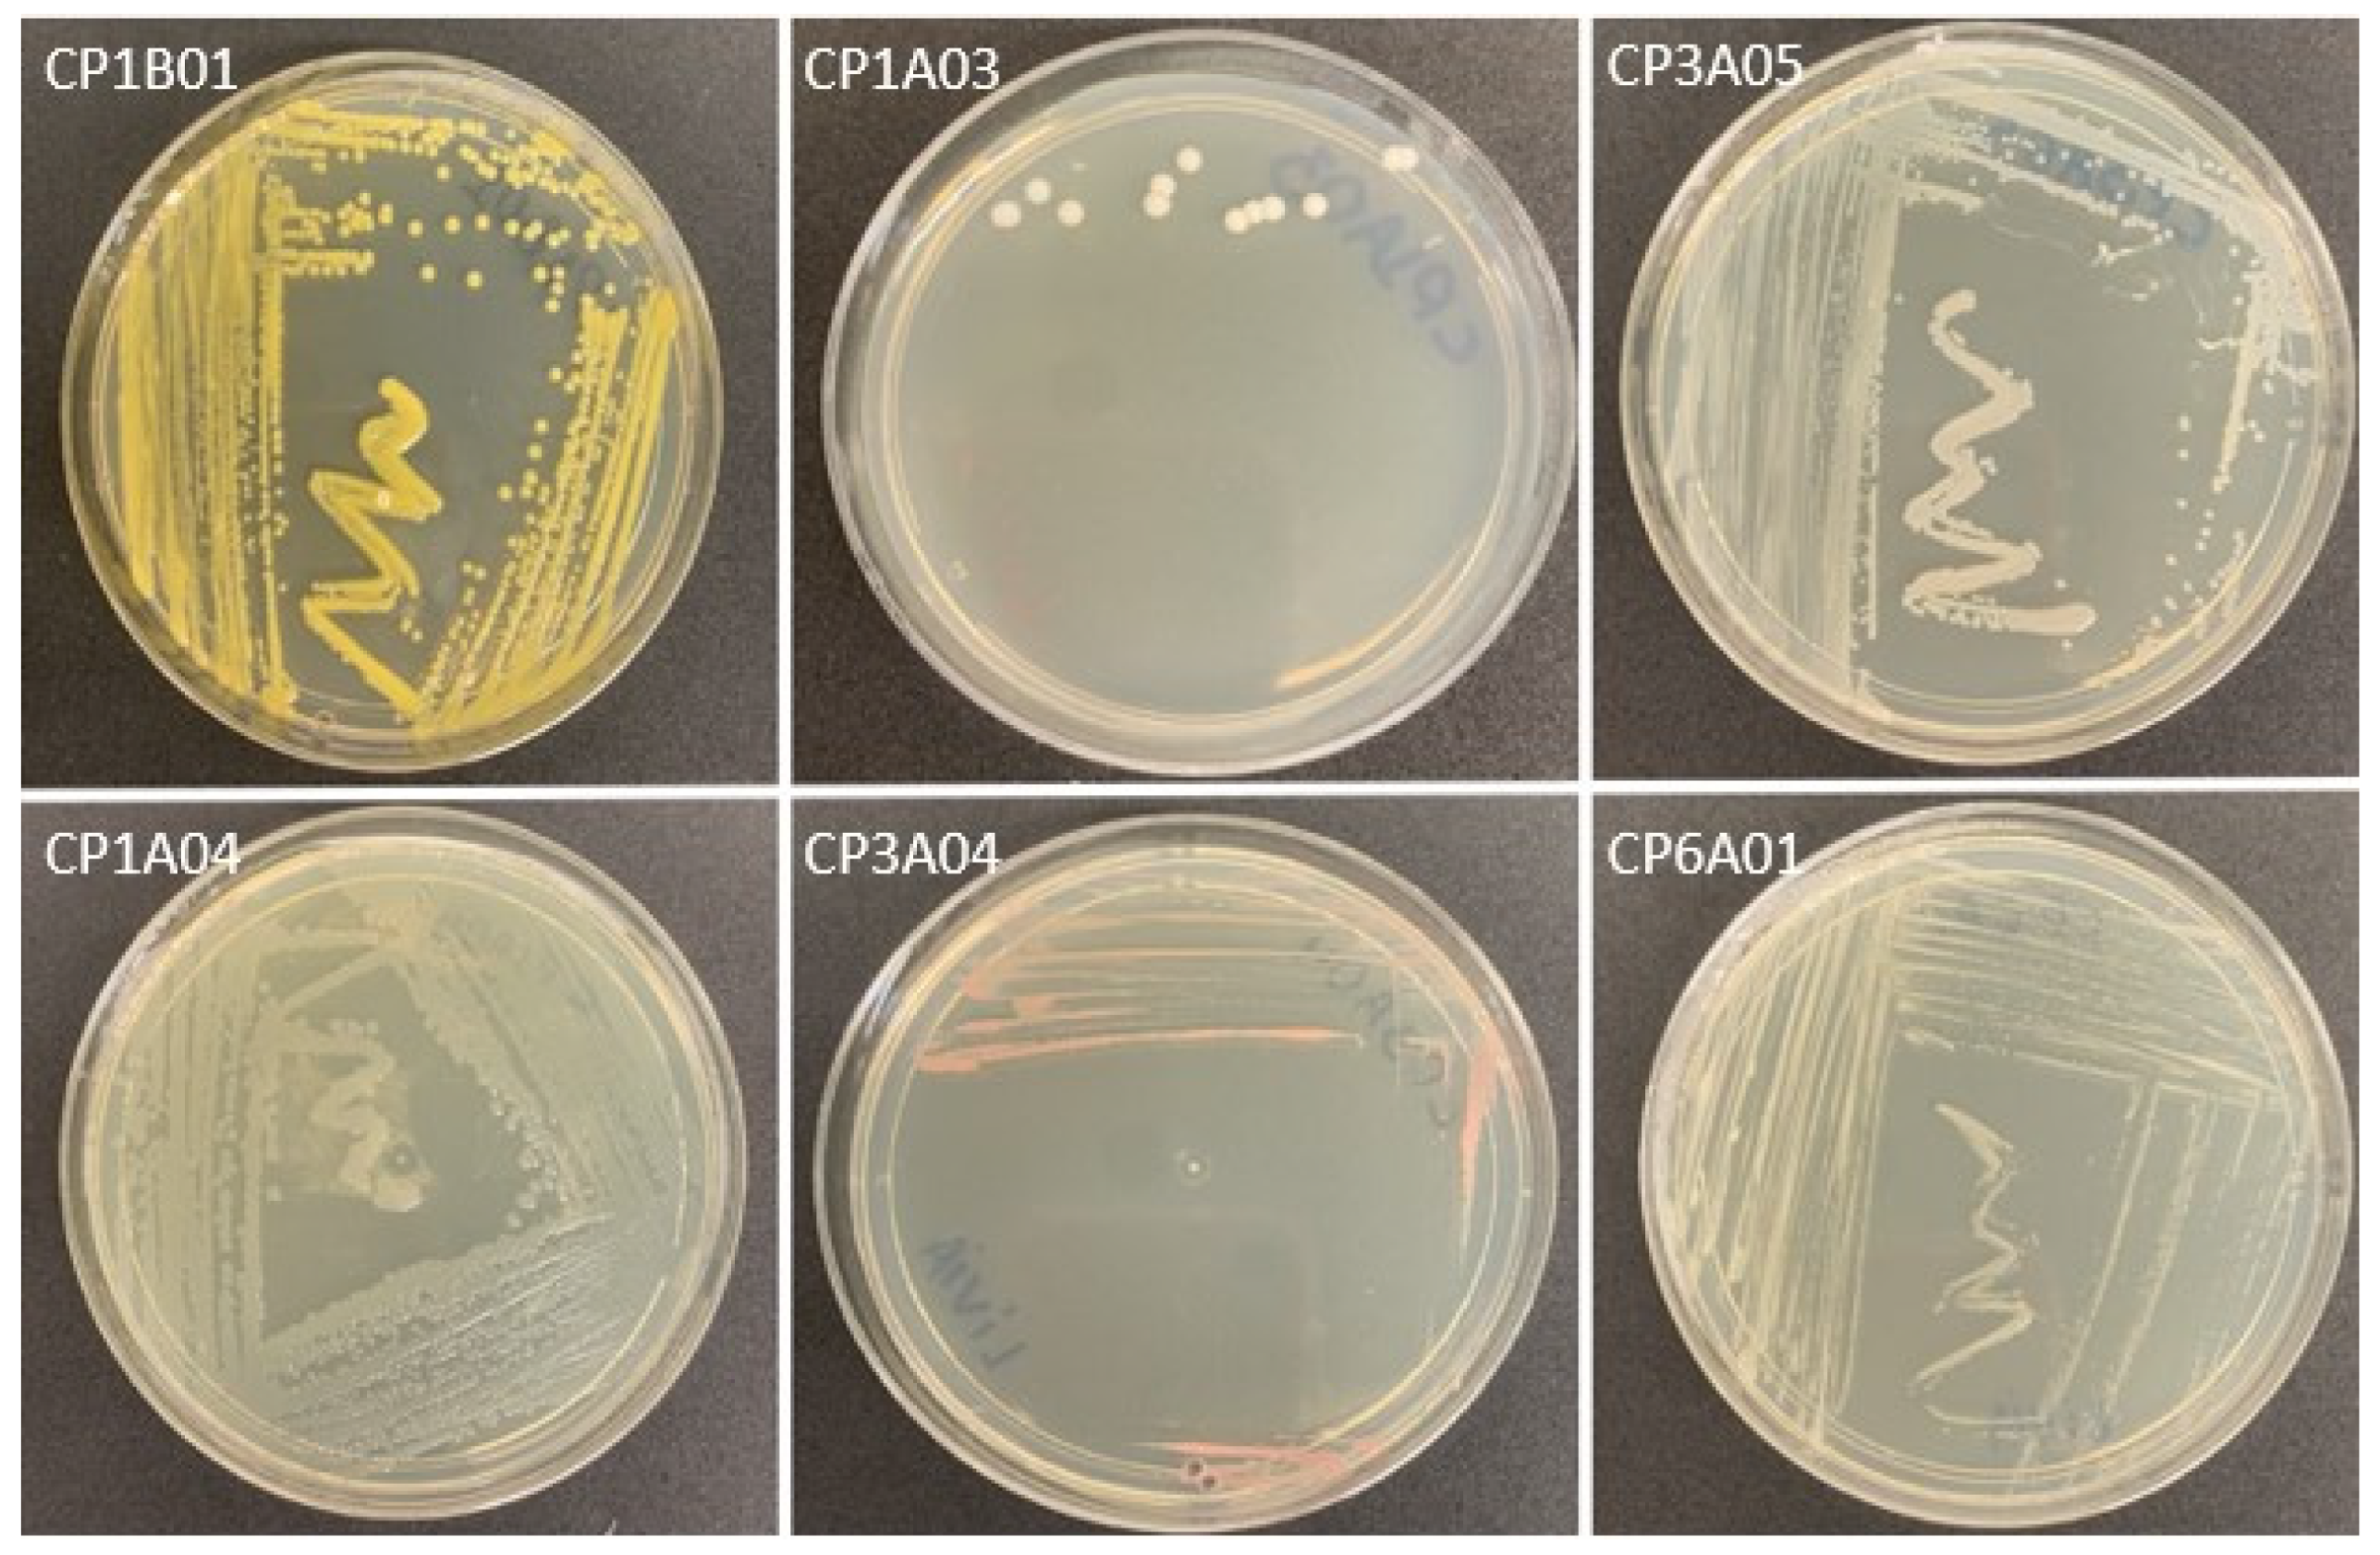
Microorganisms 13 01686 g001

Abstract
Endophytic bacteria inhabit plant tissues without damaging them and have specialized adaptation capabilities that allow them to establish themselves in this ecological niche. Endophytes produce numerous secondary metabolites with antimicrobial, anticancer, and pesticide properties, among others. In this study, endophytic bacteria were isolated and characterized from cocoa plants in a Brazilian municipality, with the view to evaluate their potential antagonistic activity on clinical bacterial strains. The isolates were identified through phenotypic analysis and molecular characterization. After bacterial isolation, it was possible to verify the presence of 11 different endophytic strains, with a bacterial load of up to 6.3 × 103 CFU/g in each plant. The morphological and biochemical profile of the isolates varied. At the taxonomic level, these bacteria showed 99% similarity with the genera Microbacterium, Curtobacterium, Pseudomonas, Bacillus, Ralstonia, and Methylobacterium. The strains of the phylum Actinobacteria, which are known for producing natural bioactive compounds with high biotechnological potential, were effective in inhibiting Staphylococcus aureus ATCC and multidrug-resistant clinical strains. This work aims to expand knowledge about endophytes, with the aim of applying them in other sectors, such as the production of compounds against resistant human pathogens.
1. Introduction
Endophytic bacteria are microorganisms, which spend all or part of their lives in plant tissues without causing any apparent damage to them [1]. Nearly all plants are thought to associate with one or more endophytic microbes [2]. However, only a few of these species have been studied for the presence of such microorganisms [3].
Endophytes originate from the existence of an environmental microbiome, coming from the rhizosphere or phyllosphere [4]. Although they may enter plants by the leaves, via stomata, the vast majority begin the colonization process through the roots [5]. Plant roots exude specific compounds (e.g., organic acids, amino acids, and flavonoids), which are recognized by rhizospheric microorganisms and trigger the migratory movement towards the interior of the plant [6].
The plant–endophyte interaction is characterized as symbiotic, as both benefit from this association [7]. The host plants house and protect the endophytes, which in turn promote the growth of plants via nitrogen fixation, phosphorus enrichment, and the synthesis of phytohormones [8]. Furthermore, they act in plant protection as biocontrollers [9], due to competition for nutrients and space; synthesis of lytic enzymes; production of other metabolites with antibiosis activity [10]; tolerance to salinity, temperatures, heavy metals, and contaminated chemicals; and other abiotic factors [11].
The development of these activities results in a specialized adaptation capacity that allows for the establishment of endophytes in this ecological niche [12]. Genomic studies related to the adaptation of bacteria to the endosphere are being developed, and it has been observed that, in general, they present a decrease in the genome [11]. In some cases, endophytes also have large plasmids, with genes involved in the synthesis and transport of amino acids that are expressed in response to changes in environmental conditions and the occurrence of stresses [13].
Thus, the metabolic profiling of endophytes in recent years has identified a wealth of secondary metabolites, including compounds such as flavonoids, carotenoids, melatonins, terpenoids, phenolics, alkaloids, and peptides [14]. These natural molecules offer prospects for a wide range of applications (antimicrobial, anticancer, antioxidant, cytotoxic, pesticide properties) and are the basis for the synthesis of effective molecules in the medical, pharmaceutical, agricultural, and other industrial sectors [15].
On the other hand, actinobacteria are considered a promising source of natural and structurally unique antimicrobials, many of which have potential for therapeutic novelties [15,16], also reported in medicinal plant endophytes [17]. Currently, actinobacteria account for approximately 80% of the synthesis of antibiotics of microbial origin, making a significant contribution to the pharmaceutical industry [18].
The search for and discovery of natural bioactive molecules with novel therapeutic mechanisms is decreasing compared to the increase in emerging infectious diseases and multidrug-resistant human pathogens [19]. However, the prospects for discovering new drug molecules can be improved by moving research to underexplored or unexplored environments [15].
Even so, most studies carried out on plants of commercial interest, such as Theobroma cacao, show that isolated endophytes are pathogenic and may put cocoa agricultural production at risk [20,21,22]. Furthermore, in the Brazilian Amazon, there is little research on the association of endophytes with this plant compared to the great plant heterogeneity existing in the region [5].
In this sense, the purpose of this work was to isolate and characterize endophytic bacteria from leaves and stem fragments of cocoa trees in order to evaluate the potential production of compounds with antagonistic activity in bacterial strains of clinical interest.
2. Materials and Methods
2.1. Collection Site
The samples were collected from a Theobroma cacao plantation (2°59′37″ S and 47°44′44″ W) located in the municipality of Paragominas. This site belongs to the southeastern mesoregion of Pará, Northern Brazil. Cocoa cultivation on this property is divided into two distinct areas: shaded and full-sun cocoa planting. Three vegetables from each planting were randomly chosen for analysis, and 12.5 g of leaves and 12.5 g of stem fragments were collected [23]. The collected material was labeled, stored in thermal boxes at 4 °C, and transported to the laboratory.
2.2. Isolation of Bacteria
A mixture of leaves and stem fragments from each plant collected was initially made to isolate the bacteria. Then, each of these underwent a superficial disinfection pre-treatment, based on washing with running water; sequential immersion in 70% ethyl alcohol for 1 min, 2% sodium hypochlorite for 4 min, and 70% ethyl alcohol for 30 s; and washing in sterile distilled water three times. Subsequently, 25 g of tissue fragments was macerated in 225 mL saline solution (NaCl 0.9%). The macerate was stirred at 200 rpm for 15 min and left to rest for another 15 min; this process occurred at room temperature. After that, the mixture was filtered using sterile gauze. From the liquid obtained from the filtrates, serial dilutions of 10−2, 10−4, and 10−6 were carried out in triplicate of them [24].
The bacteria were isolated using the streak depletion method in two culture media supplemented with Nystatin (1 μL/mL): Yeast Extract–Malt Extract agar (ISP-2) and Brain Heart Infusion (BHI) broth. They were then incubated in Petri dishes in a bacteriological oven for 25 days at 28 °C [23].
After incubation, the microorganisms were characterized macroscopically and microscopically by performing Gram staining. The biochemical profile of the isolates was analyzed by testing the production of catalase, growth from citrate as the primary source of energy, the ability to form phenyl pyruvic acid through phenylalanine, the fermentation of carbohydrates (sucrose, glucose, and lactose), and the production of hydrogen sulfide and carbon dioxide [25].
2.3. Molecular Identification
Molecular characterization was performed by extracting total genomic DNA from bacteria using the Phenol/Chloroform/Isoamyl Alcohol method [26]. Subsequently, the concentration and purity index of the genetic material were determined using a NanoDrop 2000c device (Thermo Fisher Scientific, Wilmington, DE, USA). The integrity of the genetic material was verified by electrophoresis on 1% agarose gel in 1X TAE buffer (40 nM Tris-acetate; 1 mM EDTA) and stained with ethidium bromide at 0.5 μg/mL. After that, the 16S rRNA region was amplified with the help of universal primers 8F and 1492R [27].
The products obtained by amplification were sequenced using the Sanger method. Sequence visualization was performed using the BioEdit 7.0.5 program [28]. With the same tool, multiple alignment was performed with the ClustalW method, comparing the sequences obtained with those from the public GenBank database (http://www.ncbi.nlm.nih.gov, accessed on 13 January 2024). The J Model Test 2.1.10 software [29] was initially used to develop the phylogenetic tree to select the best statistical method and model for building the tree with the help of the MEGA 11.0.10 program [30].
2.4. Antimicrobial Evaluation
The growth curve was carried out on the isolates belonging to the actinobacteria phylum to identify the stationary phase, where there is greater production of secondary metabolites [31]. The potential antimicrobial activity of the bacteria was evaluated using the diffusion test in solid media, carried out in triplicate.
The testing occurred by comparing the isolates with nine strains, 2 of which correspond to the reference strains Staphylococcus aureus (ATCC-25923) and Escherichia coli (ATCC-25922), and 7 to clinical strains of multidrug-resistant Staphylococcus aureus, Escherichia coli, Klebsiella pneumoniae, Pseudomonas aeruginosa, Enterobacter cloacae, Acinetobacter baumanii, and Serratia marcescens. The clinical strains were obtained from biological samples from João de Barros Barreto University Hospital, after approval by the Human Research Ethics Committee with procedural number CAAE78135723.6.0000.0017.
This methodology added a bacterial inoculum with a turbidity of 0.5 on the McFarland scale of ATCC and clinical strains in the exponential growth phase to Mueller–Hinton agar. After sowing, each strain using the distension method on a plate, 6 mm diameter wells were created on the surface of the seeded medium, and ISP-2 solid medium was added to each well with actinobacteria growing in the stationary phase. These plates were placed in an oven at 37 °C for 48 h to visualize bacterial development later and verify the inhibition of halo formation [32].
3. Results and Discussion
3.1. Characteristics of Isolated Strains
Of the six samples of leaves and stem fragments collected, 19 endophytic bacterial colonies were obtained, 14 (73.68%) referring to the three cocoa trees grown in full sun and 5 (26.32%) isolated from plants in a shaded area. Regarding the number of colonies per sample, values between one and seven were observed, except for one sample that showed no growth. In this way, the bacterial load obtained was up to 6.3 × 103 CFU/g, with significant differences between vegetables with and without shade (t-test = 4.943; p value = 0.004), with the load being more important in planting in full sun.
However, the sample size used in this study was insufficient to accurately determine the quantitative superiority of endophytes planted in full sun. In view of this, future studies with a larger number of samples are needed to compare these two types of cultivation.
Numerous factors can influence the colonization and promote population fluctuations in endophytes, including environmental conditions such as sunlight, water activity, temperature, and humidity [33]. Andrade et al. [34] evaluated the diversity of endophytic bacteria from Cattleya walkerina in three different environments (nature, greenhouse, and in vitro), finding differences between them, which highlights the influence of environment on the colonization capacity of endophytic bacteria.
On the other hand, the number of endophytic isolates was lower than that reported in the research by Alsultan et al. [35], which isolated up to 12 endophytic bacteria in each leaf sample. This difference in our work may be due to the mixing of stem fragments, which did not allow for homogeneous maceration, as did the work of Vera-Loor et al. [36], carried out with flower and cocoa seed tissues.
In addition, the number of endophytes of the same plant can be variable in different tissues; values found in root samples were significantly higher than those in stems and leaves [37]. On the other hand, antifungal activity tested against Ganoderma boninense was more relevant in isolates from higher tissues of the plant [38].
The characteristics of isolates were variable and can be seen in Table 1. The colonies presented different sizes and shapes, with colors that varied from white to pink, yellow, and non-pigmented, some with shine and others without. Smooth and rough textures with a soft or mucoid consistency were also found (Figure 1).
Table 1.
Morphological and biochemical characterization of endophytic bacteria strains from Theobroma cacao.
Figure 1.
Macroscopic colony characteristics of endophytic bacterial isolates of Theobroma cacao on ISP-2 agar.
In the results of our study, different colors were observed in the colonies, which may suggest the presence of pigments, possibly carotenoids, as these molecules were identified in yellowish colonies [39,40,41,42]. Similar characteristics of bacterial colonies were also found in isolates of Citrullus colocynthis (L.) Schrad with ISP-2 medium [43].
Furthermore, of the 19 colonies found, 15 isolates with different macroscopic characteristics were identified. However, only 11 were subjected to Gram staining, as 4 strains were lost in the process of replication and purification of the colonies.
Regarding Gram staining, the presence of bacilli was evident in all isolates. The variation in micromorphology was restricted to dye affinity, as five of the total isolates were Gram-positive. The majority of endophytic bacteria are Gram-positive, but it is also possible to find Gram-negative endophytic bacteria [44].
In plants of Ficus minhassae, the isolation was similar in Gram-positive and Gram-negative endophytic bacteria, classified as Actinobacteria and Proteobacter, respectively [44]. In contrast, in another study more Gram-negative strains were found [45].
The biochemical characteristics of the Gram-positive strains of catalase-positive, phenylalanine-negative, and non-H2S producing samples were similar in almost all isolates except isolate CP6A01, which showed different results in the use of citrate as a carbon source and fermentation of glucose, sucrose, and lactose. Also, variation was observed in the other isolates regarding CO2 production.
Important Gram-positive bacteria that are beneficial for plant growth showed positive catalase and citrate results, resembling the strain CP6A01 [46]. Moreover, the variation in sucrose and lactose fermentation observed in this same strain was reported in another study [47].
In the case of Gram-negatives, it can be seen that the biochemical profile was phenylalanine positive and non-H2S producing, with a difference in glucose fermentation being observed. Furthermore, strain CP1A04 showed different results from the others regarding catalase activity. In the same way, most Gram-negative endophytic bacteria can produce catalase, while a small proportion are considered catalase-negative [48].
The distinct biochemical profiles found in bacterial isolates may be atypical, as they depend on their genetic load, which is associated with the ecological niche they inhabit [49].
3.2. 16S rRNA Analysis
Identification with the sequencing of the 16S rRNA segment showed 99% similarity with reference sequences from the database, obtaining nominations at the taxonomic level of genus; these were Microbacterium (three strains), Curtobacterium, Pseudomonas (two strains), Ralstonia, Methylobacterium (two strains) and Bacillus (Figure 2).
Figure 2.
Phylogenetic tree of cultivable endophytic bacteria in T. cacao. Phylogeny based on 16S rRNA sequences obtained from isolates and the NCBI database, performed using the Maximum Likelihood method with the Jukes–Cantor model. Associated taxa were grouped in the bootstrap test (1000 replicates), and bootstrap values were greater than 50%. Evolutionary analyses were conducted in MEGA v. 11 software.
The taxonomic classification at the species level of the different isolated strains would be improved, and it would be necessary to combine other conserved genes for these differentiations, in addition to the use of the 16S rRNA gene, which is the molecular marker widely used for the taxonomic classification of prokaryotes [36]. Thus, one of the frequently isolated families of endophytes in the laboratory corresponds to the Microbacteriaceae family [50], such as our isolates.
On the other hand, some of the different genera isolated correspond to microorganisms with pathogenic capacity. In the case of Pseudomonas, depending on the type of host, it can be pathogenic or not. This bacterium can cause disease in some plants while, in others, it can live as a symbiont, developing biocontrol and growth promotion functions. In the case of humans, especially Pseudomonas aeruginosa, it is generally known as a pathogen of clinical importance [48].
In addition, the genus Methylobacterium was identified. Mostly facultative methylotrophic bacteria with pink pigmentation, this genus plays an essential role in the growth and yield of plants through the synthesis of carotenoids and the production of phytohormones [51].
Another finding of this study was the isolation of the genus Ralstonia, which is widely used in bioremediation due to its ability to decompose many toxic substances. Furthermore, this genus develops biocontrol functions like Microbacterium and Bacillus. The Bacillus genus, in particular, also presents antifungal activity for a pathogen that affects cocoa plantations [52].
Some studies isolated and identified endophytic bacteria belonging to the genera Streptomyces, Micronospora, Actinomadura, Bacillus, Paenibacillus, and Pseudomonas [3,6,53].
3.3. Antimicrobial Activity
For the bioactive molecules produced, it was necessary to know the growth kinetics of these bacteria, and it was found that the stationary phase began at 16 h, as reported by Almajali et al. [54], for the genus Curtobacterium [55]. There is not enough scientific evidence about the stationary phase time of Microbacterium.
The evaluation of the antimicrobial activity of the isolated actinobacteria was visualized by the formation of inhibition halos produced by all strains (CP1B01, CP1A02, CP3A01, and CP3A02) against Staphylococcus aureus of the reference and clinical strains. However, for E. coli of the reference and clinical strains, K. pneumoniae, P. aeruginosa, E. cloacae, A. baumanii, and S. marcescens, the same formation was not observed.
The diameters of the inhibition halos formed by Microbacterium and Curtobacterium isolates against S. aureus of the reference and clinical strains are presented in Table 2.
Table 2.
Characteristics of actinobacteria strains for evaluation of antimicrobial compound production.
A similar result showed that an actinobacteria, isolated from Ficus minhasae, inhibited the growth of S. aureus but not E. coli [44]. The importance of finding new molecules against S. aureus is due to their clinical relevance and their complications in multidrug resistance, which are a frequent health problem, allowing new possibilities for the treatment of methicillin-resistant S. aureus (MRSA) strains [56].
There are not enough articles about the use of these antibiotic-producing bacteria against clinical strains. The discovery of this type of biomolecule helps in the development of new treatment alternatives against multi-resistant strains, which can combine synthetic molecules and natural extracts [57].
In brief, actinobacteria are commonly used in the pharmaceutical industry to search for antimicrobial compounds. Due to their non-pathogenic characteristics for humans, they are used for these purposes [58,59].
4. Conclusions
In this study, it was possible to isolate 11 endophytic bacterial strains collected from the leaves and stem fragments of cocoa trees. The morphological and biochemical characterization of the isolates was varied. In the case of molecular identification, it was possible to name all strains at the genus level. Of these, four belonged to the actinobacteria group, three to the genus Microbacterium, and one to Curtobacterium. Other isolates were characterized as Pseudomanas, Bacillus, Ralstonia, and Methylobacterium.
Actinobacteria inhibited the growth of Staphylococcus aureus, proving to be effective against this bacterium. Therefore, to better understand the study of endophytes in this type of plant, it is necessary to increase the number of cocoa samples. Likewise, with these isolated strains, the extraction and chemical characterization of secondary metabolites with antibacterial potential could be carried out, in addition to being able to develop genomic analyses for functional annotation of the genes responsible for the synthesis of these antimicrobial compounds and, finally, to make comparisons in existing databases.
Author Contributions
L.F.d.S.P.: writing—original draft preparation, methodology. T.C.S.T.: investigation, visualization. O.V.C.-A.: formal analysis, validation. E.M.S.G.L.: resources. C.P.d.S.: conceptualization, funding acquisition. A.R.C.N.: supervision, writing—reviewing and editing. All authors have read and agreed to the published version of the manuscript.
Funding
This research received no external funding.
Data Availability Statement
The data presented in the study was deposited in the National Center for Biotechnology Information NCBI database (https://www.ncbi.nlm.nih.gov/), accession ID PQ412810, PP83992-P839001.
Acknowledgments
We thank the PROPESP/UFPA (Pró-Reitoria de Pesquisa e Pós-graduação/Universidade Federal do Pará) for the financial support on this paper.
Conflicts of Interest
The authors declare no competing interests.
References
- Villas Boas, D.F.; Luiz, J.H.H.; Malpass, G.R.P.; Okura, M.H.; De Souza, C.P.; Granato, A.C. Microrganismos endofíticos como fonte de compostos de interesse medicinal—Uma breve revisão. Rev. Bras. Ciência Tecnol. Inovação 2021, 5, 70–86. [Google Scholar] [CrossRef]
- Sharma, M.; Mallubhotla, S. Diversity, Antimicrobial Activity, and Antibiotic Susceptibility Pattern of Endophytic Bacteria Sourced from Cordia dichotoma L. Front. Microbiol. 2022, 13, 879386. [Google Scholar] [CrossRef]
- Li, Z.; Xiong, K.; Wen, W.; Li, L.; Xu, D. Functional Endophytes Regulating Plant Secondary Metabolism: Current Status, Prospects and Applications. Int. J. Mol. Sci. 2023, 24, 1153. [Google Scholar] [CrossRef]
- Beraldo-Borrazzo, J.; Mangolin, C.A.; Machado, M.D.F.P.D.S. Biotechnological prospection of endophytic bacteria associated with cactaceae. Rev. Ibero-Am. Ciências Ambient. 2021, 12, 567–579. [Google Scholar] [CrossRef]
- Alves-Júnior, M.; De Sousa, F.O.; Silva, T.F.; Albino, U.B.; Garcia, M.G.; Moreira, S.M.C.D.O.; Vieira, M.R.D.S. Functional and Morphological Analysis of Isolates of Phylloplane and Rhizoplane Endophytic Bacteria Interacting in Different Cocoa Production Systems in the Amazon. Curr. Res. Microb. Sci. 2021, 2, 100039. [Google Scholar] [CrossRef]
- Rutkowska, N.; Drożdżyński, P.; Ryngajłło, M.; Marchut-Mikołajczyk, O. Plants as the Extended Phenotype of Endophytes—The Actual Source of Bioactive Compounds. Int. J. Mol. Sci. 2023, 24, 10096. [Google Scholar] [CrossRef]
- Sahu, K.P.; Kumar, A.; Patel, A.; Kumar, M.; Gopalakrishnan, S.; Prakash, G.; Rathour, R.; Gogoi, R. Rice Blast Lesions: An Unexplored Phyllosphere Microhabitat for Novel Antagonistic Bacterial Species against Magnaporthe oryzae. Microb. Ecol. 2021, 81, 731–745. [Google Scholar] [CrossRef] [PubMed]
- Wu, W.; Chen, W.; Liu, S.; Wu, J.; Zhu, Y.; Qin, L.; Zhu, B. Beneficial Relationships Between Endophytic Bacteria and Medicinal Plants. Front. Plant Sci. 2021, 12, 646146. [Google Scholar] [CrossRef]
- Agrawal, S.; Bhatt, A. Microbial Endophytes: Emerging Trends and Biotechnological Applications. Curr. Microbiol. 2023, 80, 249–263. [Google Scholar] [CrossRef]
- Ali, M.A.; Ahmed, T.; Ibrahim, E.; Rizwan, M.; Chong, K.P.; Yong, J.W.H. A Review on Mechanisms and Prospects of Endophytic Bacteria in Biocontrol of Plant Pathogenic Fungi and Their Plant Growth-Promoting Activities. Heliyon 2024, 10, e31573. [Google Scholar] [CrossRef]
- Oukala, N.; Aissat, K.; Pastor, V. Bacterial Endophytes: The Hidden Actor in Plant Immune Responses against Biotic Stress. Plants 2021, 10, 1012. [Google Scholar] [CrossRef]
- Kaur, R.; Kaur, C.; Kaur, G.; Kaur, J.; Rath, S.K.; Dwibedi, V. From Microscopy to Omics: A Comprehensive Review of Tools and Techniques in Studying Endophytic Adaptation under Abiotic and Biotic Stress. J. Plant Growth Regul. 2024, 1–19. [Google Scholar] [CrossRef]
- Khare, E.; Mishra, J.; Arora, N.K. Multifaceted Interactions Between Endophytes and Plant: Developments and Prospects. Front. Microbiol. 2018, 9, 2732. [Google Scholar] [CrossRef] [PubMed]
- Watts, D.; Palombo, E.A.; Jaimes Castillo, A.; Zaferanloo, B. Endophytes in Agriculture: Potential to Improve Yields and Tolerances of Agricultural Crops. Microorganisms 2023, 11, 1276. [Google Scholar] [CrossRef] [PubMed]
- Lang, M.E.; Sibanda, T.; Louw, S.; Uzabakiriho, J.D. Antimicrobial Potential of the Endophytic Actinobacteria Isolated from Harpagophytum procumbens: A Southern African Medicinal Plant. S. Afr. J. Bot. 2023, 156, 268–277. [Google Scholar] [CrossRef]
- Nalini, M.S.; Prakash, H.S. Diversity and Bioprospecting of Actinomycete Endophytes from the Medicinal Plants. Lett. Appl. Microbiol. 2017, 64, 261–270. [Google Scholar] [CrossRef] [PubMed]
- Musa, Z.; Ma, J.; Egamberdieva, D.; Abdelshafy Mohamad, O.A.; Abaydulla, G.; Liu, Y.; Li, W.-J.; Li, L. Diversity and Antimicrobial Potential of Cultivable Endophytic Actinobacteria Associated with the Medicinal Plant Thymus roseus. Front. Microbiol. 2020, 11, 191–208. [Google Scholar] [CrossRef] [PubMed]
- Salwan, R.; Sharma, V. Molecular and Biotechnological Aspects of Secondary Metabolites in Actinobacteria. Microbiol. Res. 2020, 231, 126374. [Google Scholar] [CrossRef]
- Eshboev, F.; Karakozova, M.; Abdurakhmanov, J.; Bobakulov, K.; Dolimov, K.; Abdurashidov, A.; Baymirzaev, A.; Makhnyov, A.; Terenteva, E.; Sasmakov, S.; et al. Antimicrobial and Cytotoxic Activities of the Secondary Metabolites of Endophytic Fungi Isolated from the Medicinal Plant Hyssopus Officinalis. Antibiotics 2023, 12, 1201. [Google Scholar] [CrossRef]
- Chóez-Guaranda, I.; Espinoza-Lozano, F.; Reyes-Araujo, D.; Romero, C.; Manzano, P.; Galarza, L.; Sosa, D. Chemical Characterization of Trichoderma spp. Extracts with Antifungal Activity against Cocoa Pathogens. Molecules 2023, 28, 3208. [Google Scholar] [CrossRef]
- Khaeruni, A.; Hiqmawati, A.; Satrah, V.N.; Sutariati, G.A.K.; Wijayanto, T.; Rahni, N.M. Effectiveness and Synergistic of Endophytic Bacteria in Inhibiting the Development of Cocoa Black Pod Rot Disease (Phytophthora palmivora Bult.). AIP Conf. Proc. 2023, 2628, 120016. [Google Scholar] [CrossRef]
- Wijaya, G.; Wardani, A.K.; Eris, D. Biocontrol Activity of Endophytic Bacteria from Cocoa against Phytophthora sp. and Colletotrichum sp. Menara Perkeb. 2023, 91, 72–86. [Google Scholar] [CrossRef]
- Golinska, P.; Wypij, M.; Agarkar, G.; Rathod, D.; Dahm, H.; Rai, M. Endophytic Actinobacteria of Medicinal Plants: Diversity and Bioactivity. Antonie Van Leeuwenhoek 2015, 108, 267–289. [Google Scholar] [CrossRef] [PubMed]
- Jabborova, D.; Annapurna, K.; Fayzullaeva, M.; Sulaymonov, K.; Kadirova, D.; Jabbarov, Z.; Sayyed, R.Z. Isolation and Characterization of Endophytic Bacteria from Ginger (Zingiber officinale Rosc.). Ann. Phytomed. 2020, 9, 116–121. [Google Scholar] [CrossRef]
- Fitri, L.; Bessania, M.A.; Septi, N.; Suhartono, S. Isolation and Characterization of Soil Actinobacteria as Cellulolytic Enzyme Producer from Aceh Besar, Indonesia. Biodiversitas 2021, 22, 5169–5180. [Google Scholar] [CrossRef]
- Wilson, K. Preparation of Genomic DNA from Bacteria. Curr. Protoc. Mol. Biol. 2001, 2, 755–757. [Google Scholar] [CrossRef]
- Alves, H.D.O.; Miranda, M.D.; Polanczyk, R.A.; Nascimento, J.D.; Desiderio, J.A.; Souza, J.A.M.D. Integral Characterization of the 16S rRNA Gene of Non-Sporulating Bacteria and Its Action against Anticarsia gemmatalis Hübner (Lepidoptera: Erebidae). J. Agric. Sci. 2020, 12, 61–74. [Google Scholar] [CrossRef]
- Sofi, M.Y.; Shafi, A.; Masoodi, K. BioEdit in bioinformatics. Bioinform. Everyone 2022, 23, 231–236. [Google Scholar] [CrossRef]
- Darriba, D.; Posada, D.; Kozlov, A.M.; Stamatakis, A.; Morel, B.; Flouri, T. ModelTest-NG: A New and Scalable Tool for the Selection of DNA and Protein Evolutionary Models. Mol. Biol. Evol. 2020, 37, 291–294. [Google Scholar] [CrossRef]
- Dey, M.; Singh, D. A New Species of Cololejeunea (Hepaticae: Lejeuneaceae) from Eastern Himalaya, India. Taiwania 2008, 53, 258–263. [Google Scholar] [CrossRef]
- Arumugam, T.; Senthil Kumar, P.; Kameshwar, R.; Prapanchana, K. Screening of Novel Actinobacteria and Characterization of the Potential Isolates from Mangrove Sediment of South Coastal India. Microb. Pathog. 2017, 107, 225–233. [Google Scholar] [CrossRef] [PubMed]
- Zothanpuia; Passari, A.K.; Leo, V.V.; Chandra, P.; Kumar, B.; Nayak, C.; Hashem, A.; Abd_Allah, E.F.; Alqarawi, A.A.; Singh, B.P. Bioprospection of Actinobacteria Derived from Freshwater Sediments for Their Potential to Produce Antimicrobial Compounds. Microb. Cell Fact. 2018, 17, 68–81. [Google Scholar] [CrossRef] [PubMed]
- Afzal, I.; Shinwari, Z.K.; Sikandar, S.; Shahzad, S. Plant Beneficial Endophytic Bacteria: Mechanisms, Diversity, Host Range and Genetic Determinants. Microbiol. Res. 2019, 221, 36–49. [Google Scholar] [CrossRef] [PubMed]
- Andrade, G.V.S.; Rodrigues, F.A.; Nadal, M.C.; Dambroz, C.M.d.S.; Martins, A.D.; Rodrigues, V.A.; dos Reis Ferreira, G.M.; Pasqual, M.; Buttros, V.H.; Dória, J. Plant-endophytic bacteria interactions associated with root and leaf microbiomes of Cattleya walkeriana and their effect on plant growth. Sci. Hortic. 2023, 309, 656–670. [Google Scholar] [CrossRef]
- Alsultan, W.; Vadamalai, G.; Khairulmazmi, A.; Saud, H.M.; Al-Sadi, A.M.; Rashed, O.; Jaaffar, A.K.M.; Nasehi, A. Isolation, Identification and Characterization of Endophytic Bacteria Antagonistic to Phytophthora Palmivora Causing Black Pod of Cocoa in Malaysia. Eur. J. Plant Pathol. 2019, 155, 1077–1091. [Google Scholar] [CrossRef]
- Vera-Loor, M.; Bernal-Cabrera, A.; Vera-Coello, D.; Leiva-Mora, M.; Rivero-Aragón, A.; Morales-Díaz De Villegas, L. Árbol filogenético y características de bacterias endófitas asociadas a Theobroma cacao L. en una zona de la provincia de Esmeraldas, Ecuador. Bioagro 2021, 33, 223–228. [Google Scholar] [CrossRef]
- Xia, Y.; He, R.; Xu, W.; Zhang, J. The Zoige Pioneer Plant Leymus secalinus Has Different Endophytic Bacterial Community Structures to Adapt to Environmental Conditions. PeerJ 2023, 11, e15363. [Google Scholar] [CrossRef]
- Mardiah, I. Identification of Endophytic Bacterial Isolated from Oil Palm Plants with Anti-Fungal Activity against Ganoderma boninense. Pharmacol. Clin. Pharm. Res. 2018, 3, 41–49. [Google Scholar] [CrossRef]
- Hagaggi, N.S.A.; Abdul-Raouf, U.M. Production of Bioactive β-Carotene by the Endophytic Bacterium Citricoccus parietis AUCs with Multiple in Vitro Biological Potentials. Microb. Cell Fact. 2023, 22, 90–98. [Google Scholar] [CrossRef]
- Ibrahim, G.S.; El-Shall, F.N.; Arafa, A.A.; Shalabi, A.; El Awady, M. Bio-Production and Characterization of Carotenoid Yellow Pigment from Kocuria sp. GMA and Exploring Its Sustainable Antioxidant, Antimicrobial and Antibiofilm Properties. Egypt. J. Chem. 2024, 67, 57–68. [Google Scholar] [CrossRef]
- Kandasamy, G.D.; Kathirvel, P. Production, Characterization and in Vitro Biological Activities of Crude Pigment from Endophytic Micrococcus luteus Associated with Avicennia marina. Arch. Microbiol. 2024, 206, 26–44. [Google Scholar] [CrossRef] [PubMed]
- Muhammad, M.; Basit, A.; Majeed, M.; Shah, A.A.; Ullah, I.; Mohamed, H.I.; Khan, A.; Ghanaim, A.M. Chapter 16—Bacterial pigments and their applications. In Bacterial Secondary Metabolites; Elsevier: Amsterdam, The Netherlands, 2024; pp. 277–298. [Google Scholar] [CrossRef]
- Ali, A.R.; Bahrami, Y.; Kakaei, E.; Mohammadzadeh, S.; Bouk, S.; Jalilian, N. Isolation and Identification of Endophytic Actinobacteria from Citrullus colocynthis (L.) Schrad and Their Antibacterial Properties. Microb. Cell Fact. 2022, 21, 206–222. [Google Scholar] [CrossRef] [PubMed]
- Tallei, T.E.; Linelejan, Y.T.; Umboh, S.D.; Adam, A.A.; Muslem; Idroes, R. Endophytic Bacteria Isolated from the Leaf of Langusei (Ficus minahassae Tesym. & De Vr.) and Their Antibacterial Activities. IOP Conf. Ser. Mater. Sci. Eng. 2020, 796, 012047. [Google Scholar] [CrossRef]
- Murtado, A.; Mubarik, N.R.; Tjahjoleksono, A. Isolation and Characterization Endophytic Bacteria as Biological Control of Fungus Colletotrichum sp. on Onion Plants (Allium cepa L.). IOP Conf. Ser. Earth Environ. Sci. 2020, 457, 012043. [Google Scholar] [CrossRef]
- Sansanwal, R.; Ahlawat2, U.; Batra, P.; Wati, L.; Kaushik, P. Biochemical and Molecular Characterization of Endophytic Bacteria from Root Nodules of Mungbean (Vigna radiata). Ann. Biol. 2023, 36, 7–10. [Google Scholar] [CrossRef]
- Aureen, L.G.; Saroj, B. Microbacterium Arborescens AGSB sp. nov., Isolated from the Rhizosphere of Sand Dune Plant, Ipomoea Pes Caprae. Afr. J. Microbiol. Res. 2013, 7, 5154–5158. [Google Scholar] [CrossRef][Green Version]
- Medison, R.G.; Tan, L.; Medison, M.B.; Chiwina, K.E. Use of Beneficial Bacterial Endophytes: A Practical Strategy to Achieve Sustainable Agriculture. AIMS Microbiol. 2022, 8, 624–643. [Google Scholar] [CrossRef] [PubMed]
- Betancur, L.A.; Naranjo-Gaybor, S.J.; Vinchira-Villarraga, D.M.; Moreno-Sarmiento, N.C.; Maldonado, L.A.; Suarez-Moreno, Z.R.; Acosta-González, A.; Padilla-Gonzalez, G.F.; Puyana, M.; Castellanos, L.; et al. Marine Actinobacteria as a Source of Compounds for Phytopathogen Control: An Integrative Metabolic-Profiling/Bioactivity and Taxonomical Approach. PLoS ONE 2017, 12, e0170148. [Google Scholar] [CrossRef]
- Patel, A.; Sahu, K.P.; Mehta, S.; Javed, M.; Balamurugan, A.; Ashajyothi, M.; Sheoran, N.; Ganesan, P.; Kundu, A.; Gopalakrishnan, S.; et al. New Insights on Endophytic Microbacterium-Assisted Blast Disease Suppression and Growth Promotion in Rice: Revelation by Polyphasic Functional Characterization and Transcriptomics. Microorganisms 2023, 11, 362. [Google Scholar] [CrossRef] [PubMed]
- Zhang, C.; Wang, M.-Y.; Khan, N.; Tan, L.-L.; Yang, S. Potentials, Utilization, and Bioengineering of Plant Growth-Promoting Methylobacterium for Sustainable Agriculture. Sustainability 2021, 13, 3941. [Google Scholar] [CrossRef]
- Cruz-Hernández, M.A.; Reyes-Peralta, J.; Mendoza-Herrera, A.; Rivera, G.; Bocanegra-García, V. Characterization of a Microbacterium sp. Strain isolated from soils contaminated with hydrocarbons in the Burgos Basin, Mexico. Rev. Int. Contam. Ambient. 2021, 37, 227–235. [Google Scholar] [CrossRef]
- Anavadiya, B.; Chouhan, S.; Saraf, M.; Goswami, D. Exploring Endophytic Actinomycetes: A Rich Reservoir of Diverse Antimicrobial Compounds for Combatting Global Antimicrobial Resistance. Microbe 2024, 4, 100110. [Google Scholar] [CrossRef]
- Almajali, I.; Al-Tarawneh, A.; Qaralleh, H.; Al-limoun, M.; Al-Sarayrah, M.; Alqaraleh, M.; Rayyan, W.; Khleifat, K.; Dmour, S. Biodegradation of Phenol by Curtobacteriumflaccumfaciens: Optimizationof Growth Conditions. Pol. J. Environ. Stud. 2021, 30, 5435–5442. [Google Scholar] [CrossRef]
- Khleifat, K.; Magharbeh, M.; Alqaraleh, M.; Al-Sarayrah, M.; Alfarrayeh, I.; Al Qaisi, Y.; Alsarayreh, A.; Al-kafaween, M.A. Biodegradation Modeling of Phenol Using Curtobacterium flaccumfaciens as Plant-Growth-Promoting Bacteria. Heliyon 2022, 8, e10490. [Google Scholar] [CrossRef]
- Cheung, G.Y.C.; Bae, J.S.; Otto, M. Pathogenicity and Virulence of Staphylococcus aureus. Virulence 2021, 12, 547–569. [Google Scholar] [CrossRef]
- Jubeh, B.; Breijyeh, Z.; Karaman, R. Resistance of Gram-Positive Bacteria to Current Antibacterial Agents and Overcoming Approaches. Molecules 2020, 25, 2888. [Google Scholar] [CrossRef]
- Selim, M.S.M.; Abdelhamid, S.A.; Mohamed, S.S. Secondary Metabolites and Biodiversity of Actinomycetes. J. Genet. Eng. Biotechnol. 2021, 19, 72–84. [Google Scholar] [CrossRef]
- Zhao, P.; Xue, Y.; Gao, W.; Li, J.; Zu, X.; Fu, D.; Feng, S.; Bai, X.; Zuo, Y.; Li, P. Actinobacteria–Derived Peptide Antibiotics since 2000. Peptides 2018, 103, 48–59. [Google Scholar] [CrossRef]
Disclaimer/Publisher’s Note: The statements, opinions and data contained in all publications are solely those of the individual author(s) and contributor(s) and not of MDPI and/or the editor(s). MDPI and/or the editor(s) disclaim responsibility for any injury to people or property resulting from any ideas, methods, instructions or products referred to in the content. |
© 2024 by the authors. Licensee MDPI, Basel, Switzerland. This article is an open access article distributed under the terms and conditions of the Creative Commons Attribution (CC BY) license (https://creativecommons.org/licenses/by/4.0/).